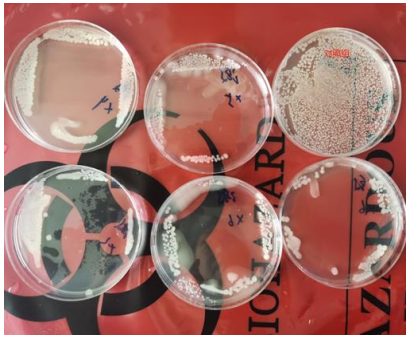

友情链接:
省市科技管理部门
其它网站平台

承德技术合同认定登记公众号
主办单位:承德市生产力促进中心 | 地址:河北省承德市行政中心西楼5层
联系电话:0314-2383069 | 成果登记咨询电话:0314-2039577
版权所有:承德市生产力促进中心 | 备案号:冀ICP备2021023221号-1 | 冀ICP备2021023221号-2
网站声明
|
建议您使用Chrome、Firefox、Edge、IE10及以上版本主流浏览器浏览本网站